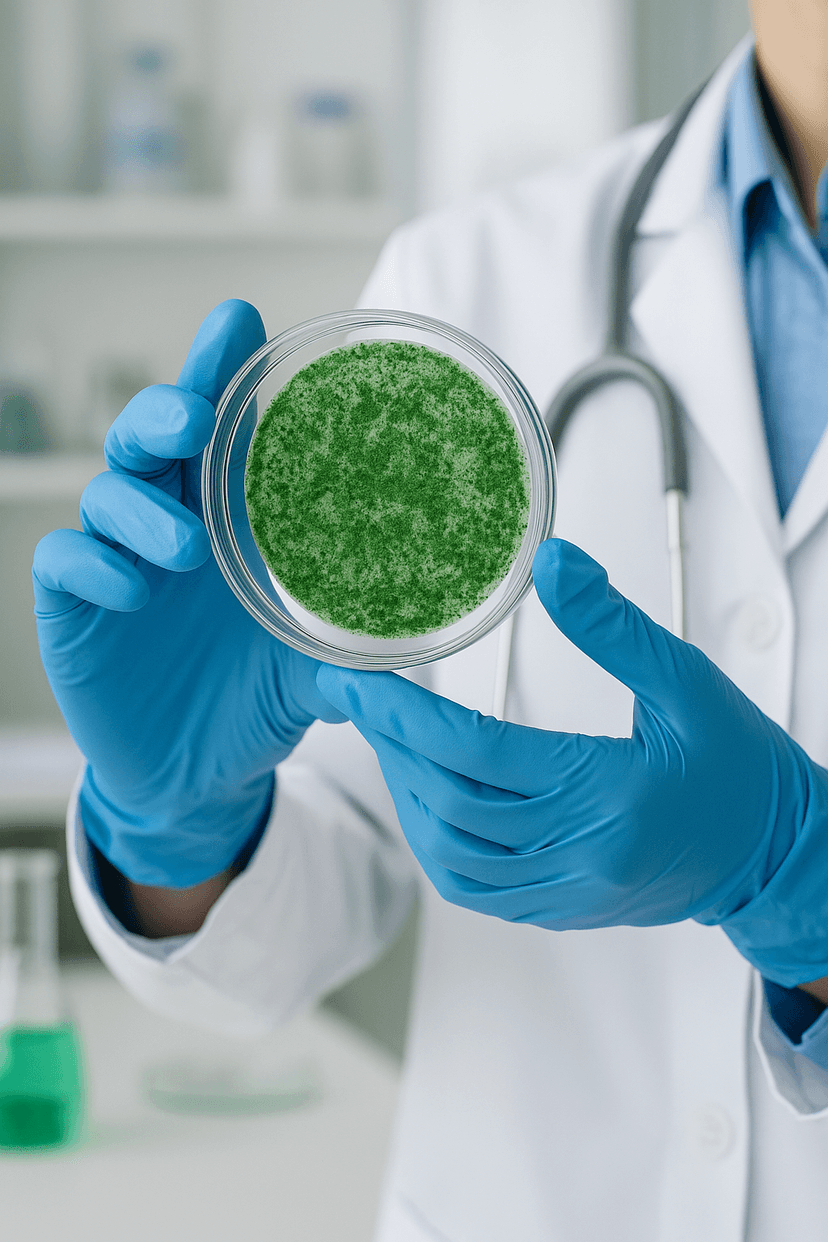

INTERNATIONAL MEDICAL SYMPOSIUM
ADVANCING CARE THROUGH RESEARCH 2026
A multi-disciplinary conference bringing clinicians, researchers and industry together to share advances in patient care.
Sustainable Health
Putting Patients First
The symposium gathers leading experts to discuss breakthroughs in diagnostics, therapeutics, and health systems. Sessions will cover clinical innovation, translational research, public health, and implementation strategies for better outcomes.
Attendees will participate in panels, workshops and poster sessions designed to accelerate collaboration between hospitals, academic centers and industry partners. The program emphasizes practical solutions that can be implemented in diverse clinical settings.
“Clinical innovation paired with pragmatic delivery is the fastest path to improving population health.”
— Dr. A. Morgan Hayes, Chair, International Medical Symposium




6000
Participants
150
Sessions
400
Speakers
135
Countries
250
Science Papers
135
Partners



Copenhagen Lessons
“How we act on this must be bold – even radical, compared with current practice. With ‘The Copenhagen Lessons’, we present 10 principles for what that means when we construct, plan and develop the built environment. The health of the planet and basic human needs are on the line, we have no time to waste.”
– Natalie Mossin
The Copenhagen Lessons consist of 10 principles for a rapid and radical change in the built environment to reach the UN’s 17 Sustainable Development Goals (SDGs). The congress demonstrated that architectural solutions are already here, contributing to sustainable communities and quality of life. However, the built environment is also an active part of the current challenges: a major consumer of energy and natural resources, and a producer of waste – and it can have a huge impact on both inequality and public health. The construction industry alone accounts for 40% of global CO₂ emissions and 35% of total waste, which calls for urgent action.
Copenhagen Lessons as PDF
Natalie Mossin, President of UIA World Congress of Architects 2023
Copenhagen Lessons

Natalie Mossin, President of UIA World Congress of Architects 2023
01: Dignity and agency for all people is fundamental in architecture, there is no beauty in exclusion.
02: People at risk of being left behind must be accommodated first when we construct, plan, and develop the built environment.
03: Existing built structures must always be reused first.
04: When new construction is necessary, it must be built for the long term.
05: We must build with materials that can be reused or recycled.
06: No virgin mineral material must be used in construction when reuse is possible.
07: No waste must be produced or left behind in construction.
08: When sourcing materials for construction, local renewable materials come first.
09: In everything we build, carbon capture must exceed carbon footprint.
10: When developing, planning, and constructing the built environment, every activity must have a positive impact on water ecosystems and clean water supply.
















FOUNDING PARTNERS





THE CONFERENCE TALKS

ADVANCES IN REGENERATIVE MEDICINE
01 Stem Cell Therapies and Tissue Engineering

AI IN CLINICAL DIAGNOSIS
02 Artificial Intelligence and Predictive Analytics

SUSTAINABLE HEALTHCARE DESIGN
03 Green Hospitals and Low-Carbon Practices

BIOMATERIALS FOR THE FUTURE
04 Innovation in Medical Device Materials

PATIENT-CENTERED TECHNOLOGIES
05 Human-Centric Digital Health Systems
NEXT WORLD CONGRESS
IS IN 2026
Go to France